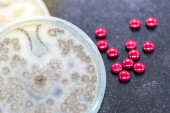

Badanie chromatografii wykorzystuje się do oddzielenia składników rośliny..

Informacje o pliku:
| Numer pliku: | 0101396604342 |
| Typ pliku/format: | Zdjęcia ( JPG ) |
| Rozdzielczość: | 5760x3840 (48,77x32,51 cm 300 dpi) |
| Kategorie: | |
| Autor: | p.thongdumhyu |